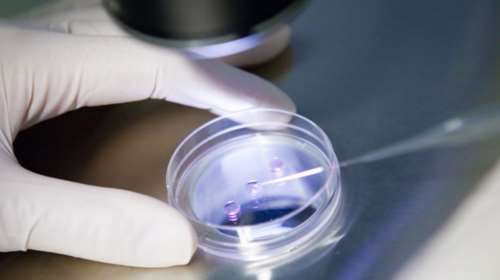
Ασυγχώρητο λάθος σε κλινική: Γονιμοποίησαν  26 γυναίκες με λάθος σπέρμα

ΕΞΩΣΩΜΑΤΙΚΗ ΓΟΝΙΜΟΠΟΙΗΣΗ
Νέες εξελίξεις στην εξωσωματική γονιμοποίηση
Καινοτομίες και νέα επιτεύγματα που αυξάνουν τις δυνατότητες επιτυχίας.
Διατροφή και εξωσωματική γονιμοποίηση: Οι τροφές που βελτιώνουν τις πιθανότητες κύησης
Γνωρίζουμε ότι οι διατροφικές μας επιλογές και οι καθημερινές συνήθειες επηρεάζουν τη γονιμότητα. Τι ισχύει όμως αναφορικά με τη διατροφή και την εξωσωματική γονιμοποίηση;
Γιατί εκτοξεύθηκαν οι γεννήσεις διδύμων - Πώς εξηγείται το ιστορικό ρεκόρ
Η αύξηση διδύμων μετά τη δεκαετία του 1980 εκτιμάται σε 71% στη Βόρεια Αμερική, 60% στην Ευρώπη και 32% στην Ασία.
Βικτώρια Χαλκίτη: Ταλαιπωρήθηκα 8 χρόνια με εξωσωματικές μέχρι να αποκτήσω τον γιο μου
Η Βικτώρια Χαλκίτη μίλησε για την προσπάθειά της να αποκτήσει παιδί και δίνει μήνυμα αισιοδοξίας σε όλες τις γυναίκες που προσπαθούν.
Ηρθε στον κόσμο το πρώτο μωρό της Be-Live- Δωρεάν βοήθεια σε υπογόνιμα ζευγάρια
Μια σπουδαία πρωτοβουλία των γιατρών Κελλάρη και Χηνιάδη
Τι δείχνει νέα επιστημονική μελέτη για τις εξωσωματικές
Δεν παίζει ρόλο μόνο η ηλικία της μητέρας, αλλά και του πατέρα, στην επιτυχία μιας εξωσωματικής.
Έλληνες γιατροί έκαναν την πρώτη τριμερή εξωσωματική
Ιστορία έγραψαν Έλληνες και Ισπανοί ιατροί καθώς ολοκλήρωσαν με επιτυχία εξωσωματική γονιμοποίηση για πρώτη φορά με γενετικό υλικό από τρία άτομα.
ΗΠΑ: Για πρώτη φορά δύο μητέρες κυοφόρησαν το ίδιο μωρό
Η μέθοδος αποκαλείται Effortless Reciprocal IVF [ελληνική απόδοση: Αβίαστη Αμοιβαία Εξωσωματική Γονιμοποίηση]
Oκτώ εκατομμύρια μωρά γεννήθηκαν με εξωσωματική γονιμοποίηση
Περισσότερα από οκτώ εκατομμύρια μωρά έχουν γεννηθεί παγκοσμίως με εξωσωματική γονιμοποίηση από το 1978 μέχρι σήμερα.
Πώς η Ελένη βοήθησε την τηλεθεάτριά της να αποκτήσει παιδί
Ποιος αποκάλυψε το γεγονός στην εκπομπή της. Η συγκίνηση της παρουσιάστριας.
Ασυγχώρητο λάθος σε κλινική: Γονιμοποίησαν 26 γυναίκες με λάθος σπέρμα
Ενα επαναλαμβανόμενο διαδικαστικό σφάλμα σε κλινική θεραπείας υπογονιμότητας, οδήγησε πιθανόν στη γονιμοποίηση ωαρίων 26 γυναικών με λάθος σπέρμα.